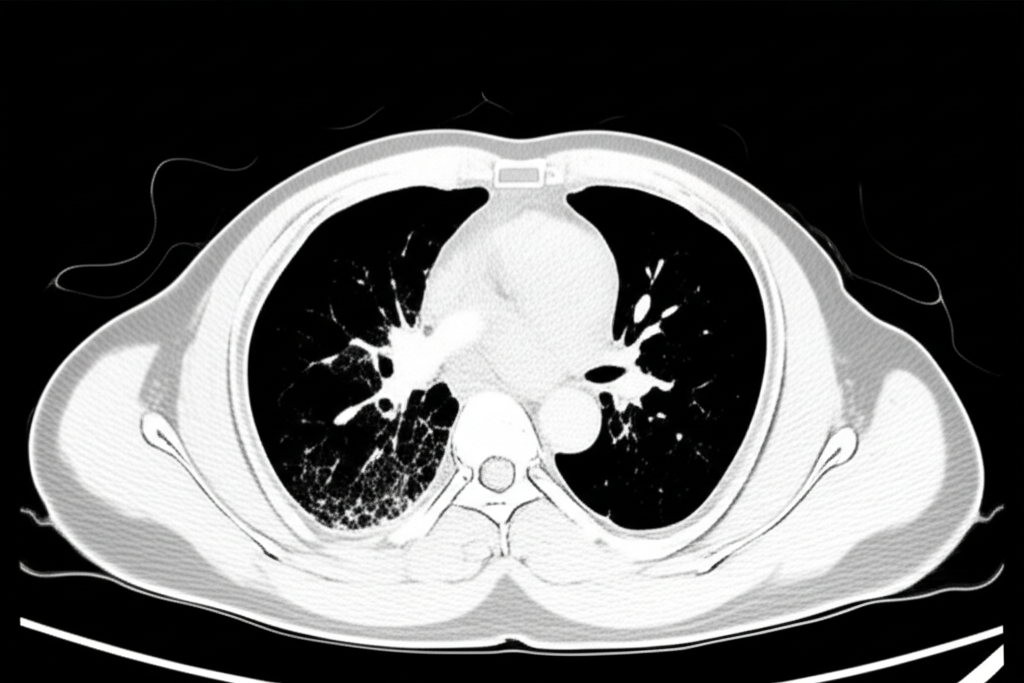
gemini
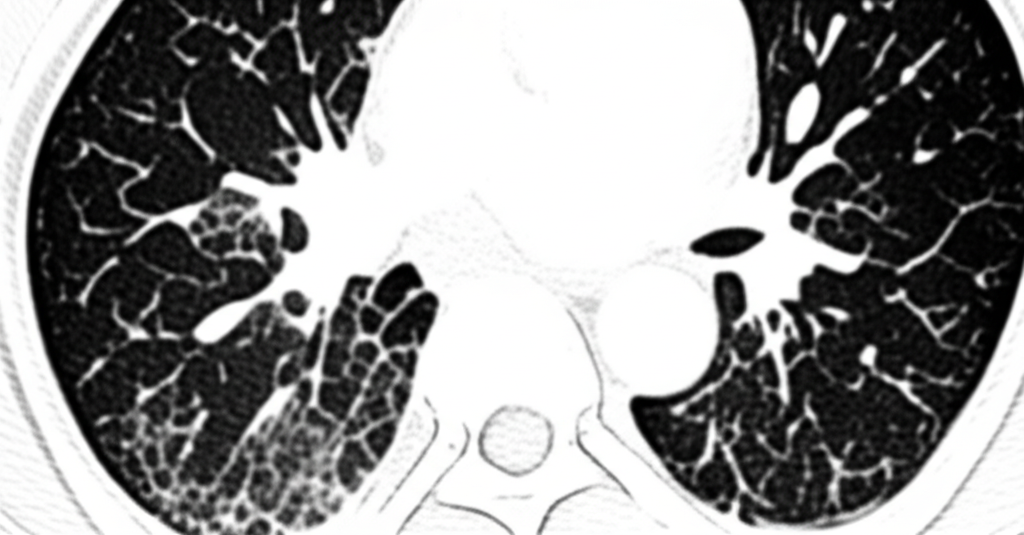
gemini
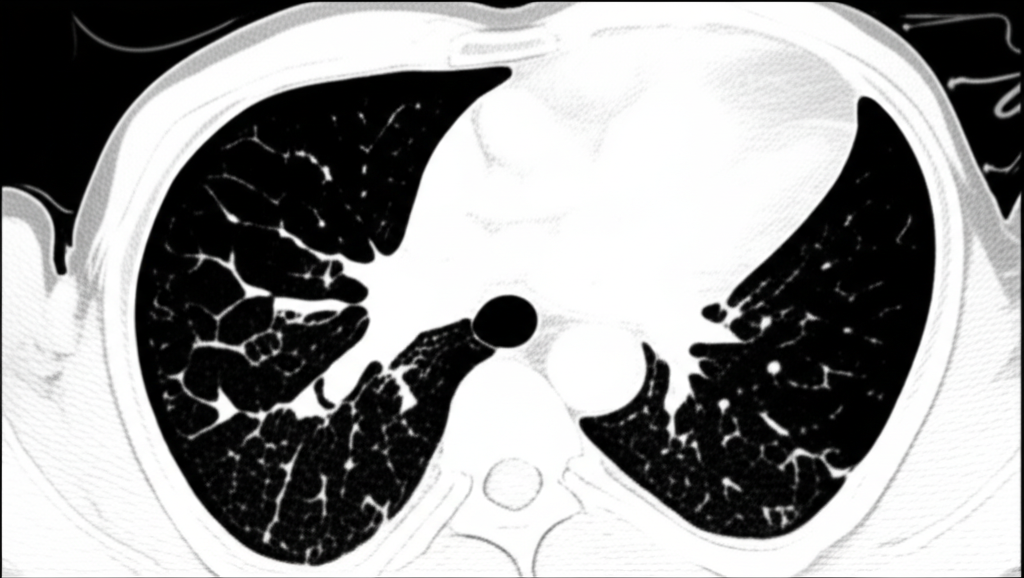
gemini

폐 CT로 알 수 있는 것: 건강 검진의 필수 요소
폐 CT는 폐 질환 진단에 매우 중요한 역할을 하는 영상 검사입니다. 흉부 X선 검사보다 훨씬 더 자세한 정보를 제공하여 폐암, 폐렴, 만성 폐쇄성 폐질환(COPD) 등 다양한 질환을 조기에 발견하고 정확하게 진단하는 데 도움을 줍니다. 건강 검진 시 폐 CT 검사를 고려하는 것은 건강한 삶을 유지하는 데 매우 현명한 선택입니다.
폐 CT 검사의 중요성
조기 진단의 기회

폐 CT로 알 수 있는 것,폐암은 초기 단계에서 증상이 거의 나타나지 않아 조기 발견이 매우 어렵습니다. 폐 CT는 작은 크기의 종양도 발견할 수 있어 조기 진단과 치료 가능성을 높여줍니다. 특히 흡연 경험이 있거나 가족력이 있는 경우, 정기적인 폐 CT 검사를 통해 폐암을 조기에 발견하는 것이 중요합니다.
다양한 폐 질환 진단
폐 CT로 알 수 있는 것은 폐암뿐만 아니라 폐렴, 결핵, 기관지확장증, 간질성 폐질환 등 다양한 폐 질환을 진단하는 데 유용합니다. 이러한 질환들은 호흡 곤란, 기침, 가래 등의 증상을 유발할 수 있으며, 심한 경우 생명을 위협할 수도 있습니다. 폐 CT 검사를 통해 이러한 질환들을 조기에 발견하고 적절한 치료를 받으면 질병의 진행을 늦추고 합병증을 예방할 수 있습니다.
수술 계획 및 치료 효과 평가
폐암 수술 전, 폐 CT는 종양의 크기, 위치, 주변 조직으로의 침범 여부 등을 정확하게 파악하는 데 사용됩니다. 이를 통해 최적의 수술 방법을 결정하고 수술 후 예후를 예측할 수 있습니다. 또한, 항암 치료나 방사선 치료 후 폐 CT를 통해 치료 효과를 평가하고 치료 계획을 조정하는 데에도 활용됩니다.
폐 CT 검사로 알 수 있는 구체적인 질환
폐암

폐 CT는 폐암의 크기, 위치, 림프절 전이 여부 등을 정확하게 파악하여 병기를 결정하는 데 중요한 역할을 합니다. 조기 폐암의 경우 수술적 절제를 통해 완치를 기대할 수 있으며, 폐 CT는 이러한 조기 진단에 결정적인 기여를 합니다.
폐렴
폐 CT는 폐렴의 종류와 범위를 파악하고, 합병증 발생 여부를 확인하는 데 유용합니다. 특히 면역력이 약한 환자나 노인의 경우, 폐렴이 심각한 합병증으로 이어질 수 있으므로 폐 CT 검사를 통해 정확한 진단과 치료 계획을 수립하는 것이 중요합니다.
만성 폐쇄성 폐질환 (COPD)
폐 CT는 COPD 환자의 폐기종 정도, 기관지 확장 여부, 폐렴 발생 여부 등을 평가하는 데 사용됩니다. 이를 통해 COPD의 진행 정도를 파악하고, 적절한 치료 계획을 수립하여 환자의 삶의 질을 향상시킬 수 있습니다.
결핵
폐 CT는 결핵 병변의 위치, 크기, 공동 형성 여부 등을 파악하는 데 유용합니다. 특히 흉부 X선 검사에서 발견하기 어려운 초기 결핵 병변을 발견하는 데 도움이 되며, 약물 치료 효과를 평가하는 데에도 활용됩니다.
간질성 폐질환

폐 CT는 간질성 폐질환의 종류와 범위를 파악하고, 질병의 진행 정도를 평가하는 데 중요한 역할을 합니다. 간질성 폐질환은 폐 섬유화를 유발하여 호흡 곤란을 악화시킬 수 있으므로, 폐 CT 검사를 통해 조기에 진단하고 적절한 치료를 받는 것이 중요합니다.
폐 CT 검사 시 주의사항
방사선 노출
폐 CT 검사는 방사선을 사용하므로 임산부나 임신 가능성이 있는 여성은 검사 전에 반드시 의료진에게 알려야 합니다. 또한, 불필요한 방사선 노출을 줄이기 위해 필요한 경우에만 검사를 받는 것이 좋습니다.
조영제 부작용
일부 폐 CT 검사에서는 조영제를 사용하여 영상의 질을 향상시킵니다. 그러나 조영제에 알레르기 반응이 있는 경우 부작용이 발생할 수 있으므로, 과거 조영제 부작용 경험이 있는 경우 반드시 의료진에게 알려야 합니다.
검사 전 준비사항
폐 CT 검사 전에는 금식이나 특별한 준비가 필요하지 않은 경우가 많습니다. 그러나 병원마다 검사 전 준비사항이 다를 수 있으므로, 검사 전에 병원의 안내를 따르는 것이 중요합니다.
폐 CT 검사 관련 FAQ
Q: 폐 CT 검사는 얼마나 자주 받아야 하나요?
A: 폐 CT 검사 빈도는 개인의 건강 상태, 흡연 여부, 가족력 등에 따라 다릅니다. 흡연 경험이 있거나 폐암 가족력이 있는 경우, 매년 정기적인 폐 CT 검사를 받는 것이 좋습니다. 건강 상태에 대한 자세한 상담은 전문의와 상의하는 것이 좋습니다.
Q: 폐 CT 검사 비용은 얼마인가요?
A: 폐 CT 검사 비용은 병원, 검사 종류 (저선량 CT, 조영제 CT 등)에 따라 다릅니다. 일반적으로 10만원에서 30만원 정도입니다. 자세한 비용은 해당 병원에 문의하는 것이 가장 정확합니다.
Q: 폐 CT 검사 결과는 언제 알 수 있나요?
A: 폐 CT 검사 결과는 병원마다 다르지만, 보통 1~2일 후에 알 수 있습니다. 검사 결과를 확인하고 전문의와 상담하여 필요한 경우 추가 검사나 치료 계획을 수립할 수 있습니다.
Q: 폐 CT 검사 시 통증이 있나요?
A: 폐 CT 검사는 통증이 없는 검사입니다. 검사 시간은 10~15분 정도로 짧으며, 편안하게 누워 있으면 됩니다. 조영제를 사용하는 경우, 일시적으로 열감이나 메스꺼움이 느껴질 수 있지만 대부분 금방 사라집니다.
결론
폐 CT는 폐 질환을 조기에 발견하고 정확하게 진단하는 데 매우 중요한 검사입니다. 특히 폐암의 조기 진단에 효과적이며, 다양한 폐 질환의 진단 및 치료 계획 수립에 도움을 줍니다. 건강 검진 시 폐 CT 검사를 고려하여 건강한 삶을 유지하시기 바랍니다. 정기적인 검진은 건강을 지키는 가장 확실한 방법입니다. 건강한 삶을 위해 지금 바로 폐 CT 검사를 고려해보세요.
심장 CT로 알 수 있는 모든 것 검사 방법, 진단 질환, 주의사항
심장 CT로 알 수 있는 모든 것: 건강 검진부터 질환 진단까지심장 건강은 우리 삶의 질을 결정하는 중요한 요소 중 하나입니다. 심장 질환은 예방과 조기 진단이 매우 중요하며, 이를 위해 심장 CT
cc.moneylife2234.com
대상포진 초기증상
대상포진 초기증상, 놓치지 말고 빠르게 대처하세요!대상포진은 수두-대상포진 바이러스(Varicella-zoster virus, VZV)가 몸 속에 잠복해 있다가 면역력이 약해졌을 때 재활성화되어 발생하는 질환입니
cc.moneylife2234.com
기흉이란? 원인, 증상, 치료 및
기흉이란 무엇일까요? 원인, 증상, 치료 및 예방 방법 완벽 분석기흉은 폐를 둘러싼 흉막강 내에 공기가 차는 질환입니다. 이로 인해 폐가 압박되어 정상적인 호흡을 방해받게 됩니다. 기흉은 다
cc.moneylife2234.com